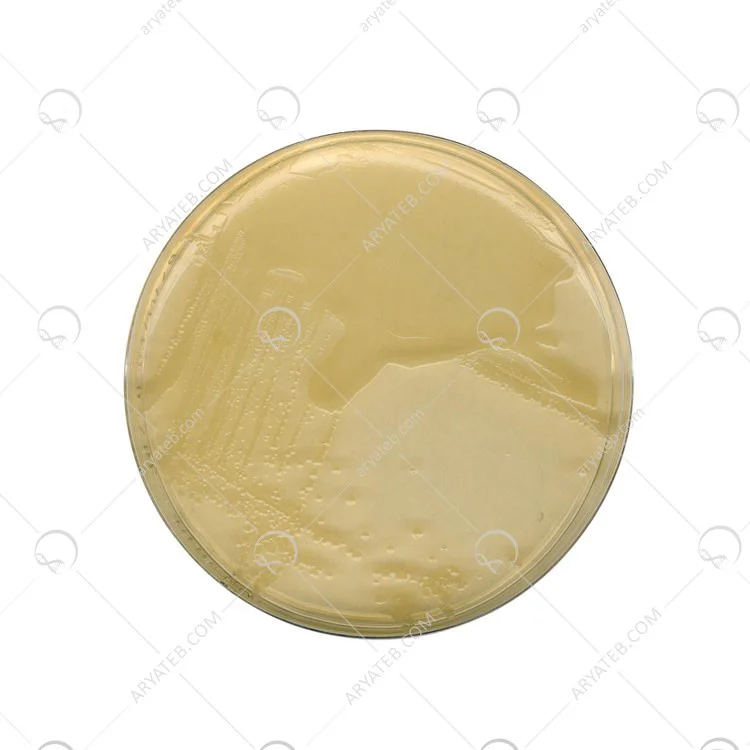

محیط کشت ال بی آگار
محیط کشت LB agar
محیط کشت LB آگار، گونهای جامد از محیط رایج Lysogeny Broth (LB) است. این محیط در آزمایشهای مولکولی و میکروبیولوژی، بهویژه برای کشت Escherichia coli استفاده میشود. نامهای دیگری مانند Luria-Bertani، Lennox یا صرفاً L Broth نیز برای آن بهکار میرود.
۲. تاریخچه و منشأ این محیط
این محیط در سال ۱۹۵۱ توسط Giuseppe Bertani معرفی شد، ابتدا با عنوان Lysogeny Broth برای مطالعه ویروسهای باکتریوفاژ (مانند فاژ P1) طراحی گردید. بعدها به یکی از استانداردهای رایج در آزمایشگاههای بیولوژی مولکولی و میکروبیولوژی تبدیل شد.
۳. ترکیبات محیط LB آگار (فرمول استاندارد)
الف) ترکیبات پایه (برای ۱ لیتر)
-
Tryptone (پپتون کیسئینی): ۱۰ گرم
-
Yeast extract (عصاره مخمر): ۵ گرم
-
Sodium chloride (NaCl): بسته به نوع فرمول:
-
Miller: ۱۰ گرم
-
Lennox: ۵ گرم
-
Luria: ۰.۵ گرم
-
-
Agar (برای محیط جامد): بین ۱۲ تا ۱۵ گرم (معمولاً ۱۵ گرم استفاده میشود)
ب) ترکیبات مفید برای کاربردهای خاص
-
گلوکز: گاهی در نسخههای اولیه تا ۱ گرم برای افزایش رشد سلولی وجود داشت.
-
CaCl₂ یا MgCl₂: در تهیه محیطهای فاژی یا کشت پلاسمید کاربرد دارد.
-
آنتیبیوتیک، X-gal و IPTG: جهت گزینش کلونیهای دارای پلاسمید و نمایش رنگ (blue-white screening).
۴. آمادهسازی LB آگار: مرحلهبهمرحله
۱. ترکیبات خشک را در ۱ لیتر آب مقطر حل کنید.
۲. Agar را اضافه کرده و مخلوط را بجوشانید تا کاملاً حل شود.
۳. محیط را در دمای ۱۲۱ درجه سانتیگراد و فشار مناسب، به مدت ۱۵ دقیقه اتوکلاو کنید.
۴. پس از خنک شدن تا حدود ۵۰–۶۰ °C، در صورت نیاز آنتیبیوتیک یا مواد حساسنشانگر را اضافه کنید.
۵. محیط را داخل پتریدیشهای استریل بریزید و اجازه دهید جامد شود.
۵. کاربردهای محیط LB آگار
-
ایزوله کلنیها: مشاهده و شمارش کلنیهای باکتری و بررسی مورفولوژی آنها.
-
تعیین و جداسازی پلاسمید: با افزودن آنتیبیوتیک، فقط باکتریهای حامل پلاسمید رشد میکنند. همچنین تست آبی/سفید (Blue-White Screening) با IPTG و X-gal قابل انجام است.
-
کاربرد آموزشی: در آزمایشگاههای آموزشی برای نمایش رشد باکتریها یا پروژههای پایه مورد استفاده قرار میگیرد.
-
پلاکتست فاژ: برای جداسازی و شمارش پلاکهای باکتریوفاژ کاربرد دارد.
۷. نکات کیفیت و ایمنی در استفاده
-
pH: معمولاً بین ۷ تا ۷.۵ تنظیم میشود.
-
استریلسازی صحیح: الزامی است و از آلودگی جلوگیری میکند.
-
افزودنیهای حساس (مثل آنتیبیوتیکها): باید بعد از خنک شدن محیط اضافه شوند.
-
محیطهای جایگزین: مانند TB یا 2xYT غنیتر هستند، اما LB آگار به دلیل سادگی و اثربخشی همچنان پرکاربردترین محیط است.
۸. چرا LB آگار همچنان محبوب است؟
-
سادگی، اقتصادی بودن و کارایی بالا برای بسیاری از آزمایشها.
-
در دسترس بودن در قالب پودر آماده یا محیط آماده مصرف.
-
قابلیت تطبیقپذیری بالا و امکان سفارشیسازی بسته به شرایط آزمایش.
۹. جمعبندی نهایی
-
محیط LB آگار یک محیط پایه و پرکاربرد برای رشد باکتریها، بهویژه E. coli است.
-
از ترکیبات سادهای چون پپتون، عصاره مخمر، نمک و آگار تشکیل شده است.
-
فرمولهای مختلف (Miller، Lennox، Luria) تفاوت اصلیشان در مقدار نمک است.
-
در پژوهشهای مولکولی، آموزشی، و آزمایشهای پلاسمیدی کاربرد فراوان دارد.
-
رعایت اصول استریل و انتخاب فرمول مناسب، تضمینکننده بهترین عملکرد این محیط است.
آدرس ایمیل شما منتشر نخواهد شد. فیلدهای الزامی علامت گذاری شده اند *